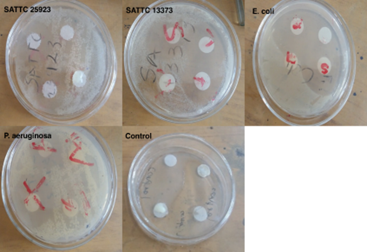

Research Article
Pharmacological and Genotoxic Potentials of a Locally Made Oily Cream in Ghana
1 Department of Pharmacology and Toxicology, School of Pharmacy, College of Health Sciences, University of Ghana, Legon, Accra, Ghana.
2 Department of Nursing, University of Health of Health and Allied Sciences, School of Nursing and Midwifery, Volta Region, Ghana.
3 Department of Biochemistry and Forensic Sciences, School of Chemical and Biochemical Sciences, C. K. Tedam University of Technology and Applied Sciences (CKT-UTAS), Navrongo, Ghana.
*Corresponding Author: Seidu A. Richard, Department of Biochemistry and Forensic Sciences, School of Chemical and Biochemical Sciences, C. K. Tedam University of Technology and Applied Sciences (CKT-UTAS), Navrongo, Ghana.
Citation: Enyan D., Gbande S., Seidu A. Richard, Benoit B. N’guessan. (2026). Pharmacological and Genotoxic Potentials of a Locally Made Oily Cream in Ghana, Journal of BioMed Research and Reports, BioRes Scientia Publishers. 10(1):1-11. DOI: 10.59657/2837-4681.brs.26.222
Copyright: © 2026 Seidu A. Richard, this is an open-access article distributed under the terms of the Creative Commons Attribution License, which permits unrestricted use, distribution, and reproduction in any medium, provided the original author and source are credited.
Received: December 01, 2025 | Accepted: December 20, 2025 | Published: January 05, 2026
Abstract
Introduction: Cosmeceuticals describes products that have cosmetic value and pharmaceutical potential. The use of shea butter, coconut oil, castor oil and others are in the increase on the market. Thus, we formulated a novel oily cream and determine its physicochemical properties, phytochemical constituents, antibacterial, antioxidant and anti-inflammatory properties as well as its genotoxic potential.
Materials and method: The formulated oily cream is made up of a mixture of shea butter, coconut oil, carrot infused oil, avocado oil, castor oil, vanilla essential oil and olive oil; of which the all above oils were purchased commercially. Physicochemical analysis was also done to identify the various physical properties of the oily cream. The antioxidant activity was analysed with use of 2, 2-diphenyl-1-picrylhydrazyl (DPPH) scavenging assay which reduces DPPH in the presence of a hydrogen donating antioxidant. The anti-bacterial activity was determined using the disk diffusion method with four different strains. Skin prick test was also used for the anti-inflammatory activity whiles Ames test was used for the genotoxic potential.
Results: The oily cream showed anti-inflammatory activity by significantly reducing the wheal diameter using acetylcholine (p < 0.001) and histamine (p < 0.001) as allergens respectively in the skin prick test. The oily cream also showed no genotoxic potential. We also observed that the cream has no antioxidant and anti-bacterial properties.
Conclusion: The results showed that the oily cream has anti-inflammatory properties and no genotoxic potential. It also showed that the cream has no antioxidant and anti-bacterial properties.
Keywords: anti-inflammatory; antioxidant, antimicrobial; genotoxic; oily cream
Introduction
Cosmeceuticals describes products that have cosmetic value and pharmaceutical potential (Gao et al., 2008). They are mainly beauty products that have pharmaceutical grade compounds or natural compounds that have pharmacological effect on the skin and hair. Consumers, especially women are willing to pay a premium for skin and hair care products and are now one of the industries growing rapidly in the world today. The Food and Drug Board does not acknowledge the term "cosmeceutical" although the cosmetic industry prefers to use this word to denote cosmetic products that have been identified to have therapeutic or drug-like benefits (Dureja et al., 2005) .
Active ingredients for cosmetics are constantly being developed by big and small corporations engaged in pharmaceuticals, biotechnology, natural products, and cosmetics, while advances in the field and knowledge of skin biology and pharmacology have facilitated the cosmetic industry's development of novel active compounds more rapidly (Cosmeceuticals, 2011). Anticipated features of cosmeceutical agents are novelty, safety, efficacy, formulation stability, as well as patent protection. Also, metabolism within skin as well as reasonable manufacture abilities are considered (Draelos, 2012). Regulatory agencies have not yet officially documented cosmeceuticals, notwithstanding the rapid proliferation of "cosmetic" products and their intended pharmaceutical activities as well as dermatologic knowledge base that renders obsolete earlier distinctions between cosmetics and drugs although attempt has been made to review the different types of cosmeceuticals and their regulation(Draelos, 2009; Rivers, 2008).
Herbs as well as spices have been used in preserving as well as augmenting human beauty because herbs have many advantageous properties such as sunscreen, moisturizing, anti-cellulite, antiaging, antioxidant, as well as antimicrobial effects (Gediya et al., 2011). Also, herbal products are mild, biodegradable, and have low toxicity profile as compared with synthetic cosmetic products (Verma and Singh, 2008). Thus, research is being done to enhance their properties by way of uncooperating newer approaches, which could improve both their aesthetic function and their performance as cosmetic agents (Müller et al., 2000). In recent times, most of these products have been made out of botanicals (Kapoor, 2005) since the synthetic ones has numerous side effect in the long run. Hence, the use of shea butter, coconut oil, castor oil and others are in the increase on the market(Shu, 1998). We formulated a novel oily cream and determine its physicochemical properties, phytochemical constituents, antibacterial, antioxidant and anti-inflammatory properties as well as its genotoxic potential.
Materials and Methods
This research was conducted at the Department of Pharmacology and Toxicology, University of Ghana School of Pharmacy. Ethical review board of the Department of Pharmacology and Toxicology, University of Ghana School of Pharmacy approved the study. All the ingredients used in the study were purchased from the local market in Accra, the capital of Ghana. The formulated oily cream is made up of a mixture of shea butter, coconut oil, carrot infused oil, avocado oil, castor oil, vanilla essential oil and olive oil at equal proportions.
Phytochemical Screening
Reducing sugars test (Fehling’s test)
Petroleum ether was used to dissolve the oily cream (0.5 g in 5ml) and Fehling’s solution (A and B) was added to it in a test tube. It was then heated for some time and detected for a brick red colour change(Ayoola et al., 2008) .
Test for anthraquinones
Petroleum ether was used to dissolve the oily cream (0.5 g in 5ml) and boiled with 10 ml sulphuric acid (H2SO4). After that, it was then mixed with 5 ml of chloroform. The chloroform layer was then put into a test tube and 1 ml of dilute ammonia added. The solution was then detected for changes in colour(Ayoola et al., 2008).
Test for terpenoids (Salkowski test)
Petroleum ether was used to dissolve the oily cream (0.5 g in 5ml). Two (2) ml of chloroform was then added to the mixture. About 3ml of concentrated H2SO4 was carefully added to form a layer. Appearance of a reddish-brown colouration at the junction where they met indicated the presence of terpenoids (Ayoola et al., 2008) .
Test for flavonoids
Petroleum ether was used to dissolve the oily cream (0.5 g in 5ml). About 5ml of dilute ammonia was added to the mixture then one (1) ml of concentrated sulphuric acid was also added. Appearance of a yellow colouration disappearing upon standing gave a positive test (Ayoola et al., 2008).
Test for tannins
Petroleum ether was used to dissolve the oily cream (0.5 g in 5ml). It was then boiled and few drops of 0.1 percentage ferric chloride was added. The presence of a brownish green or a blue-black colouration gave a positive test(Ayoola et al., 2008).
Test for alkaloids
Petroleum ether was used to dissolve the oily cream (0.5g in 5ml) and boiled. About 2ml of dilute ammonia and 5ml of chloroform was then added and then mixed gently to extract the alkaloid base. The chloroform layer formed was extracted with 10 ml of acetic acid. It was then observed for a reddish-brown precipitate with Dragendorff’s reagent(Ayoola et al., 2008).
Physicochemical Analysis
Colour and Odour Determination
Colour of the cream was determined by physical observation in day light (Engdaw and Mohammed). Odour of the cream was determined by organoleptic evaluation with the nose (Engdaw and Mohammed)
Refractive Index Determination
Refractive index of the melted cream was determined using the Abbe refractometer. Two drops of the melted cream were transferred to the prism using a syringe. Readings were read and recorded after 5 minutes (Engdaw and Mohammed) .
Total Acid Number (TAN) Determination
50 ml of petroleum ether was added to 2.5g of the oily cream and transferred into a flask and well shaken. It was then titrated against 0.1N KOH using phenolphthalein as an indicator. KOH was added until a pink colour was seen for a few seconds. The total acid number was then evaluated using the formula below (Engdaw and Mohammed): Acid number = V*N*56.1/W. Where: V = volume of potassium hydroxide used, N = normality of Potassium hydroxide, W = weight in g of the sample
Determination of Peroxide Value
3g of the sample was weighed and transferred into an Erlenmeyer flask with a glass stopper. 50ml of glacial acetic: chloroform in the ratio 3:2, 1ml of freshly prepared saturated potassium iodide solution and 100ml of distilled water were added and thoroughly shaken. It was then titrated against 0.1M sodium thiosulfate using 1ml starch solution as an indicator. The indicator was added towards the end of titration while the pale straw colour is still present. A blank was also carried out. The peroxide value was calculated using the formula below: Peroxide value = (V1-V0) *c*1000*T/m. Where: V1 = volume of sodium thiosulfate used in main test, V0 = volume of sodium thiosulfate used in blank test, c = molarity of the sodium thiosulfate, T = titre value of the sodium thiosulfate solution, m = weight of the cream weighed
Saponification Value Determination
2 g of the melted cream was weighed and dissolved with petroleum ether and 25 ml of alcoholic potassium hydroxide added. A reflux condenser was connected to the flask and heated for one hour with periodic shaking. A clear solution indicated the completion of saponification.1 ml of 1 % phenolphthalein indicator was added to the heated solution and titrated against 0.5 M hydrochloric acid (HCl) until it turned colourless. A blank titration was carried out. The Saponification value was calculated with the formula below (Engdaw and Mohammed): Saponification value = b-a/m*8.05. Where b = 0.5 N HCl required (ml) by the blank, a = 0.5 N HCl required (ml) by the sample.
Stability testing
Samples of the formulation were kept at 8oC, 25oC, 40oC and 55oC.This was done to determine the effect of storage conditions on the cream (Di Mambro and Fonseca, 2005).
Creaming and Coalescence
10g of the cream was kept in a container and stored at room temperature for three (3) months. Physical stability was detected after a week, one month, two months and three months of storage (Dickinson and Miller, 2001).
pH determination
A pH meter was used to determine the pH value of cream under different conditions (Langmuir, 1971).
Antioxidant Analysis
The 2, 2-diphenyl-1-picrylhydrazyl (DPPH) radical scavenging assay is used to determine the antioxidant activity of a substance (Sharma and Bhat, 2009).This method is sensitive and simple. It measures compounds that are radical scavengers. The antioxidant activity is directly proportional to the disappearance of DPPH in the test sample (Ak and Gülçin, 2008). Butylated Hydroxyl (BHT) was used as a standard antioxidant.
Determination of 2, 2-diphenyl-1-picrylhydrazyl (DPPH) radical scavenging activity
Each well of the micropipette plate was labelled with the identity of the sample and BHT.100uL of the extract dilution and 20nM BHT which was a positive control were added to the well.100 Ul of DPPH was then added and plate was tapped gently. The plate was covered with an aluminium foil and kept in the dark for 20 minutes. Absorbance was then read at 517nm (Sharma and Bhat, 2009). The percentage antioxidant activity was calculated with the formula below:
sample/Acontrol) *100. Where: Asample is the absorbance of the test compounds, Acontrol is the absorbance of the control reaction
Anti-bacterial activity
Anti-bacterial susceptibility tests are used to determine which specific antibiotics a particular bacterium is sensitive to. The disc diffusion method is used to determine the sensitivity of bacteria to antibiotics. In this method, discs impregnated with antibiotics are placed on top of the agar where the bacterial strains have been dispersed. Clear zones around disc after incubation is a measure of the effectiveness of the antibiotic or sample(De Beer and Sherwood, 1945).
The anti-bacterial activity was determined using the disc diffusion method. The micro-organisms (SATTC 25923, SATTC 13373, E. coli and P. aeruginosa) were then sub-cultured in a nutrient agar medium by creating a slant in a test tube and incubating at 37C for 24 hours. 0.1ml of the sub-cultured organism was inoculated into a test tube containing 10ml of normal saline.1ml of the solution was then transferred into a test tube containing 4.5ml of normal saline. Again, 1ml of this solution was then transferred into a test containing 9.5ml of normal saline. This was repeated for all the other organisms. Agar plates were poured and made to set. 4 small discs were then autoclaved and impregnated with 2 drops of the melted sample, 2 drops of melted shea butter 3 drops of a melted negative control and a drop of ciprofloxacin solution using 4 different syringes. The surface of the set agar was then streaked with the discs were then placed top of the set agar and labelled. It then left undisturbed for about 30minutes. This was repeated for the other organisms. A control was also done. The plates were then incubated at 37C for 24 hours and zones of inhibition were read (De Beer and Sherwood, 1945).
Anti-inflammatory Activity (Skin Prick Test)
Skin prick test is an important experimental procedure used to confirm sensitivity of a person to a particular substance. This is used in the search to determine the anti-inflammatory activity of a substance(Heinzerling et al., 2013).The allergens used in this case were histamine and acetylcholine (PETERS and SILVERMAN, 1946). Wheal formation on the skin of the guinea pigs would be expected upon injection of these allergens. Test sample would be used to treat the induced inflammation and then compared to a standard drug (Heinzerling et al., 2013).
Animal Model: Eight (8) male guinea pigs and seven (7) female guinea pigs of weight 400-600g were purchased from the Animal Experimental Unit at the Centre for Plant Medicine Research (CPMR). These animals were fed with Sankofa pellet feeds and tap water. Animals were divided into three (3) groups: control, test and standard groups, with five (5) guinea pigs in each group. Fur of the animals were removed from the dorsal region of the trunk of the animals with a pair of scissors and shaving stick twenty-four (24) hours before the test. Care was taken to avoid cutting the skin and only healthy animals were used for this study.
Half a gram of the cream was applied to six (6) cm2 area of the skin of the test group by means of rubbing with the index finger for about fifty (50) times twice daily for three days. After that, 0.1ml of 100ug of histamine was injected at the patches the cream was applied. The patches were then observed for the presence of wheal. The same was done for 0.1ml of 100ug acetylcholine. Diclofenac gel and distilled water were used as the standard and control respectively. Wheal diameter was measured using a pair of dividers and a ruler. Measurements were in millimetres (Bonette et al., 2001).
Genotoxic potential
The EPBI’s Muta-Chromoplate was used. Salmonella typhimurium carries mutation involved with histidine synthesis. Sample would be term mutagenic when it is able to revert this state. Colouration upon completion of experiment is purple. Change in colour from purple to yellow shows some degree of mutagenicity (Greim et al., 1980).
Mutagenic test-Muta-chromoplate procedure
Re-hydration of the dried bacteria and pre-incubation: Using aseptic techniques, two bottles of growth media were opened. Also, both vials of lyophilized bacteria were opened. The growth media were transferred into the vials of bacteria and mixed. The vials were ten covered with rubber stoppers and incubated at 37C overnight.
Sample preparation and setting up test plate: A sample of the cream was dissolved with 5% DMSO (1mg in 100ml). The solution was filtered using a 0.22Um membrane filter.
Preparation of reaction mixture: The reaction mixture comprised of Muta-Chromoplate components; A-E inclusive. The components were measured and mixed aseptically in the sterilized reaction mixture bottle supplied with the kits as shown in Table 1.
Table 1: Show the kits used for the Muta-Chromoplate components
| Components | Reagents | Quantities |
| A | Davis-Mingoli salts (concentrates) 22ml (2 units) | 43.24ml |
| B | D-glucose 10 ml (1 unit) | 9.50 ml |
| C | Bromocresol purple 7 ml (1 unit) | 4.76 ml |
| D | D- Biotin 4ml (1 unit) | 2.38 ml |
| E | L-Histidine 200ul (1 unit) | 0.12 ml |
Dispensing samples and reaction mixture into tubes (Muta-Chromoplate Assay)
5 µL of Salmonella typhimurium TA98 teat strain which had grown overnight was added to the treatment tubes containing the 5% DMSO extract of the cream and mixed thoroughly. The content of each tube was poured into a sterile multi-channel pipette reagent boat.200ul aliquots of the mixture were dispensed into each well of a 96-well sterile microplate using a multi-channel pipette. Plates were then labelled to help in identification. The plates were then covered with the lid and sealed in a sterile airtight plastic bag to prevent evaporation. The plates were then incubated at 37C for 6 days. Results were read for each day (Byrd et al., 2013).
Results
Phytochemical properties
The test cream contained flavonoids, alkaloids and terpenoids. However, glycosides, tannins and anthraquinones were absent (Table 2).
Table 2: Show the phytochemical, Physicochemical properties and the temperature stability of the cream
| The phytochemical properties of the cream. Note: Positive (+) = Present, negative (-) = Absent | ||||||
| Test | Results | |||||
| Flavonoid | + | |||||
| Alkaloids | + | |||||
| Terpenoids | + | |||||
| Fehling's | - | |||||
| Tannins | - | |||||
| Anthraquinones | - | |||||
| The Physicochemical properties of the cream | ||||||
| Test | Results | |||||
| Saponification | 2.415 | |||||
| Peroxide | 0.01667 | |||||
| Total acid number | 3.1416 | |||||
| Refractive index | 1.4705 | |||||
| pH | 5.4 | |||||
| Colour | Cream | |||||
| Odour | Vanilla scented | |||||
| The Stability of the cream at various temperature | ||||||
| Days | Temperature(◦C) | |||||
| 4ºC | 25ºC | 40ºC | 55ºC | |||
| 7 | caked | unchanged | melted | melted | ||
| 14 | caked | unchanged | melted | melted | ||
| 21 | caked | unchanged | melted | melted | ||
| 28 | caked | unchanged | melted | melted | ||
| Time Intervals (Weeks to months) | Temperature (25◦C) | |||||
| 1 week | unchanged | |||||
| 1 month | unchanged | |||||
| 2 months | unchanged | |||||
| 3 months | unchanged | |||||
Physicochemical properties
Characteristic values were obtained for the various physicochemical tests (Table 2). Values such as 2.415, 0.01667, 3. 1416, and 1.4705 were observed for the saponification test, peroxide test, total acid number, and refractive index respectively. The pH of the cream was 5.4 with a creamy colour and vanilla scented.
Temperature of stability of the cream
We observed that the cream remained unchanged at 25ºC, was caked at 4ºC and got melted at 40ºC and 55ºC (Table 2). Furthermore, we observed that the test cream remained unchanged a after 3months when subjected to room temperature (Table 2).
Anti-inflammatory Activity (Skin Prick Test)
The anti-inflammatory activity of the formulated oily cream was evaluated using a skin prick test with acetylcholine and histamine as allergens. The results were compared to a control group (distilled water) and a standard group (diclofenac gel). The mean wheal diameters and statistical significance are presented in Table 3 & 4 and Figure 1.
Figure 1: Show anti-inflammatory activity of the oily cream: The oily cream and diclofenac gel significantly reduced the wheal diameter compared to the control group (p less than 0.001) in both acetylcholine and histamine-induced inflammation.
Acetylcholine-Induced Inflammation
The oily cream significantly reduced the wheal diameter by 74.03% compared to the control group (p less than 0.001). The standard drug (diclofenac gel) reduced the wheal diameter by 76.1 percentage compared to the control group (p less than 0.001). Table 3 and Figure 1.
Table 3: Acetylcholine-Induced Inflammation
| Group | Mean Wheal Diameter (mm) | Standard Deviation | p-value (vs. Control) |
| Control | 5.10 | 0.15 | - |
| Test (Oily Cream) | 1.34 | 0.12 | < 0.001 |
| Standard (Diclofenac) | 1.24 | 0.11 | < 0.001 |
Histamine-Induced Inflammation
The oily cream significantly reduced the wheal diameter by 88.57% compared to the control group (p less than 0.001). The standard drug (diclofenac gel) reduced the wheal diameter by 90.48 percentage compared to the control group (p less than 0.001). Table 4 and Figure 1.
Table 4: Histamine-Induced Inflammation
| Group | Mean Wheal Diameter (mm) | Standard Deviation | p-value (vs. Control) |
| Control | 6.04 | 0.12 | - |
| Test (Oily Cream) | 0.74 | 0.10 | < 0> |
| Standard (Diclofenac) | 0.64 | 0.09 | < 0> |
Antioxidant Activity (DPPH Assay)
The antioxidant activity of the oily cream was evaluated using the 2,2-diphenyl-1-picrylhydrazyl (DPPH) radical scavenging assay. Butylated hydroxytoluene (BHT) was used as a positive control. The results are presented in Table 5. We observed that the test cream did not show any yellow colouration but remained purple but BHT which was used as the positive control showed some traces of yellow. The EC50 calculated after absorbance read were 0.0032 mg/ml and > 10 mg/ml for BHT and the test cream respectively (Figure 2).
Table 5: DPPH Radical Scavenging Activity
| Sample | EC50 (mg/ml) | Antioxidant Activity |
| BHT (Positive Control) | 0.0032 | High |
| Oily Cream | > 10 | None |
Figure 2: Show the Antioxidant of the BHT and the oily cream: The EC50 calculated after absorbance read were 0.0032 mg/ml and > 10 mg/ml for BHT and the test cream respectively.
DPPH Radical Scavenging Activity
Despite containing flavonoids and terpenoids, the cream showed no antioxidant activity, possibly due to compound degradation, solubility issues, test-specific mechanisms, or insufficient active compound concentrations for DPPH detection (Table 5 and Figure 2).
Antibacterial Activity (Disk Diffusion Method)
The antibacterial activity of the oily cream was evaluated using the disk diffusion method against four bacterial strains: Staphylococcus aureus ATCC 25923, Staphylococcus aureus 13373, Escherichia coli NCTC 10418, and Pseudomonas aeruginosa 599. Ciprofloxacin was used as a positive control. The results are presented in Table 6, Figure 3 & 4.
Table 6: Zones of Inhibition
| Bacterial Strain | Oily Cream | Shea Butter | Negative Control | Ciprofloxacin |
| Staphylococcus aureus ATCC 25923 | 0 | 0 | 0 | 24.4 |
| Staphylococcus aureus 13373 | 0 | 0 | 0 | 25.2 |
| Escherichia coli NCTC 10418 | 0 | 0 | 0 | 40.0 |
| Pseudomonas aeruginosa 599 | 0 | 0 | 0 | 20.0 |
Figure 3: Show regions of clear zone surrounding disc impregnated with this solution: The oily cream exhibited no antibacterial activity against the tested bacterial strains, as indicated by the absence of zones of inhibition
Zones of Inhibition
The oily cream exhibited no antibacterial activity against the tested bacterial strains, as indicated by the absence of zones of inhibition. Ciprofloxacin, the positive control, demonstrated strong antibacterial activity against all strains (Figure 3 & 4).
Figure 4: Show regions of clear zone surrounding disc impregnated with this solution: The oily cream exhibited no antibacterial activity against the tested bacterial strains, as indicated by the absence of zones of inhibition. Note: X- Positive control (ciprofloxacin), M- Negative Control, S- Shea butter, D- Test cream
Genotoxic Potential
The micro-titre plate was observed from the third to sixth day. No change in colour was observed. Hence, test cream has no mutagenic potential (Table 7 and Figure 5).
Table 7: Show the Genotoxic Potential of the cream
| The Genotoxic Potential of the cream | ||||
| Test | NUMBER OF REVERTANTS | |||
| DAY 3 | DAY 4 | DAY 5 | DAY 6 | |
| Positive control | + | + | + | + |
| Negative control | - | - | - | - |
| Oily cream extract | - | - | - | - |
| Note: Positive (+) means colour change and Negative (-) means no colour change | ||||
Figure 5: Show the genotoxic activity of the oily cream: No change in colour was observed.
Discussion
In our study, the test cream contained flavonoids, alkaloids and terpenoids. However, glycosides, tannins and anthraquinones were absent. We observed that the cream remained unchanged at 25ºC, was caked at 4ºC and got melted at 40ºC and 55ºC. Furthermore, we observed that the test cream remained unchanged a after 3months when subjected to room temperature. The cream was slightly acidic with a creamy colour and vanilla scented.
Kirby-Bauer antibiotic testing also known as disk diffusion antibiotic sensitivity testing uses antibiotic-impregnated discs to test whether specific bacteria are susceptible to specific antibiotics (Hudzicki, 2009). The micro-organisms (SATTC 25923, SATTC 13373, E. coli and P. aeruginosa) were used. They were sub-cultured in a nutrient agar medium by creating a slant in a test tube and incubated at 37C for 24 hours (Biemer, 1973). The process of sub-culturing involves transferring the microbes from one growth media to another, offering the microbes a fresh supply of nutrients on a solid or liquid medium. Sub-culturing was used to prolong the life as well as or increase the quantity of cells in the culture. Subculture is therefore utilized to generate a new culture with a lower density of cells than the originating culture. These were then grown on a set nutrient agar.
Notably, each microbe colony signifies a single species of microorganism, originating from the proliferation of a single cell on the agar surface. This defined as well as isolated colony is called a pure culture and is a fundamental preliminary point in microbiological research. If the bacteria are susceptible to the specific antibiotic an area of well-defined media where bacteria are not able to grow surrounds the disc, which is called the zone of inhibition. In this experiment, 4 small discs were impregnated with the calculated drops of ciprofloxacin solution which was the positive control, shea butter, a negative control which is a cream on the market and also the test cream respectively (Reller et al., 2009). From the results, it was seen that only ciprofloxacin solution was able to inhibit the growth of all the bacterial strains. This was indicated by a region of clear zone surrounding disc impregnated with this solution. The others showed no zones of inhibition. This indicates that the strains used are no susceptible to them.
Clinicians can use this test results to choose suitable antibiotics to treat a specific infection in a patient (Jorgensen, 1993). Anti-inflammatory denotes the ability of a substance to reduce inflammation or swelling. The skin prick test was used. It helps to demonstrate an allergic response to a specific allergen (Heinzerling et al., 2013). The allergens used in this case were acetylcholine and histamine. The cream was applied twice daily for three (3) days. Injection of these allergens caused a wheal and flare formation. This type of hypersensitivity is IgE mediated. Here, mast cells and basophils coated by IgE are ‘sensitized.’ Later exposure to the same allergen cross-links with the bound IgE on sensitized cells resulting in degranulation and the secretion of pharmacologically active mediators such as histamine, leukotriene and prostaglandin that act on the surrounding tissues. The principal effects of these products are vasodilation and smooth-muscle contraction. The reaction may be either local or systemic and symptoms vary from a mild skin irritation to sudden death from anaphylactic shock (Skoner, 2001).
We observed that the control, which was distilled water did not decrease the wheal diameter formed by any of the allergens. However, the oily cream significantly reduced the wheal diameter by 74.03% compared to the control group (p < 0>p < 0>p < 0>p < 0 href="https://en.wikipedia.org/wiki/Radical_(chemistry)">free-radical molecules. It is commonly used in the antioxidant assay. DPPH is a well-known radical, hence, is used as an indicator. The DPPH radical has a deep violet colour in solution, and it becomes colourless or pale yellow when the test substance has antioxidant property (Molyneux, 2004).
Antioxidants are the compounds which inhibit free radicals by interfering in any one of the three main phases of the free radical mediated oxidative process such as initiation, propagation as well as termination (Brand-Williams et al., 1995). We observed that the test cream did not show any yellow colouration but remained purple but BHT which was used as the positive control showed some traces of yellow. The EC50 calculated after absorbance read were 0.0032 mg/ml and > 10 mg/ml for BHT and the test cream respectively. The EC50 is the concentration at which 50% of the radicals have been scavenged. This shows that at a concentration greater than 10mg/ml, 50% of radicals would be scavenged by the test cream, which is about three thousand (3000) times higher than that of BHT. Hence, the cream showed no antioxidant activity.
Ames’s test was used to determine the genotoxic potential of the cream. It was named after its developer, Bruce Ames. The bacterium used in the test is a strain of Salmonella typhimurium that carries a defective (mutant) gene making it unable to synthesize the amino acid histidine . Test sample would be termed mutagenic when it is able to revert this state (Brendler-Schwaab et al., 2004). In this experiment, the EBPI Muta-Chromo-plate was used. The initial colouration expected after the experiment is purple. A change from the purple colouration to yellow indicates a level of mutagenicity. The micro-titre plate was observed from the third to sixth day. No change in colour was observed. Hence, test cream has no mutagenic potential.
Conclusion
The results showed that the oily cream has anti-inflammatory properties and no genotoxic potential. It also showed that the cream has no antioxidant and anti-bacterial properties.
Ethical consideration: Ethical review board of the Department of Pharmacology and Toxicology, University of Ghana School of Pharmacy approved the study
Declarations
Consent for participation
Not applicable.
Patient consent for publication
Not applicable
Availability of Data
The data used in this paper is available by the corresponding author on reasonable demand.
Competing interests
All the authors have no competing interest to disclose.
Funding Source
This work has no funding or financial source.
Author contributions
D.E., and S.A.R. wrote the manuscript; D.E and B.B.N. designed the research; D.E. performed the research; D.E and S.G. analyzed the data; S.A.R., S.G, and B.B.N. contributed new reagents/analytical tools.
Acknowledgements
None
References
- Ak, T., & Gülçin, İ. (2008). Antioxidant and radical scavenging properties of curcumin. Chemico-Biological Interactions, 174(1):27–37.
Publisher | Google Scholor - Ayoola, G., Coker, H., Adesegun, S., Adepoju-Bello, A., Obaweya, K., Ezennia, E., & Atangbayila, T. (2008). Phytochemical screening and antioxidant activities of some selected medicinal plants used for malaria therapy in Southwestern Nigeria. Tropical Journal of Pharmaceutical Research, 7(3):1019–1024.
Publisher | Google Scholor - Biemer, J. J. (1973). Antimicrobial susceptibility testing by the Kirby–Bauer disc diffusion method. Annals of Clinical & Laboratory Science, 3(2):135–140.
Publisher | Google Scholor - Bonette, K., Rodabaugh, B., & Wilson, C. W. (2001). Dermal irritation and sensitization. In Handbook of toxicology (171).
Publisher | Google Scholor - Brand-Williams, W., Cuvelier, M.-E., & Berset, C. (1995). Use of a free radical method to evaluate antioxidant activity. LWT – Food Science and Technology, 28(1):25–30.
Publisher | Google Scholor - Brendler-Schwaab, S., Czich, A., Epe, B., Gocke, E., Kaina, B., Müller, L., Pollet, D., & Utesch, D. (2004). Photochemical genotoxicity: Principles and test methods—Report of a GUM task force. Mutation Research/Reviews in Mutation Research, 566(1):65–91.
Publisher | Google Scholor - Byrd, C. M., Dai, D., Grosenbach, D. W., Berhanu, A., Jones, K. F., Cardwell, K. B., Schneider, C., Wineinger, K. A., Page, J. M., & Harver, C. (2013). A novel inhibitor of dengue virus replication that targets the capsid protein. Antimicrobial Agents and Chemotherapy, 57(1):15–25.
Publisher | Google Scholor - Kim, S.-K. (Ed.). (2011). Cosmeceuticals: Trends and prospects.
Publisher | Google Scholor - De Beer, E. J., & Sherwood, M. B. (1945). The paper-disc agar-plate method for the assay of antibiotic substances. Journal of Bacteriology, 50:459–467.
Publisher | Google Scholor - Di Mambro, V. M., & Fonseca, M. J. (2005). Assays of physical stability and antioxidant activity of a topical formulation added with different plant extracts. Journal of Pharmaceutical and Biomedical Analysis, 37(2):287–295.
Publisher | Google Scholor - Dickinson, E., & Miller, R. (2001). Food colloids: Fundamentals of formulation. Royal Society of Chemistry.
Publisher | Google Scholor - Draelos, Z. D. (2009). Cosmeceuticals: Undefined, unclassified, and unregulated. Clinics in Dermatology, 27(5):431–434.
Publisher | Google Scholor - Draelos, Z. D. (2012). Cosmetics, categories, and the future. Dermatologic Therapy, 25(3):223–228.
Publisher | Google Scholor - Dureja, H., Kaushik, D., Gupta, M., Kumar, V., & Lather, V. (2005). Cosmeceuticals: An emerging concept. Indian Journal of Pharmacology, 37(3):155–159.
Publisher | Google Scholor - Engdaw, K. A. M. A. D., & Mohammed, A. (n.d.). Chemical constituents, physicochemical properties and antibacterial activity of leaves essential oil of Ocimum urticifolium.
Publisher | Google Scholor - Gao, X.-H., Zhang, L., Wei, H., & Chen, H.-D. (2008). Efficacy and safety of innovative cosmeceuticals. Clinical Dermatology, 26:367–374.
Publisher | Google Scholor - Gediya, S. K., Mistry, R. B., Patel, U. K., Blessy, M., & Jain, H. N. (2011). Herbal plants: Used as cosmetics. Journal of Natural Products and Plant Resources, 1(1):24–32.
Publisher | Google Scholor - Greim, H., Göggelmann, W., Summer, K., & Wolff, T. (1980). Mutagenicity testing with Salmonella microsome test. Archives of Toxicology, 46(1):31–40.
Publisher | Google Scholor - Heinzerling, L., Mari, A., Bergmann, K.-C., Bresciani, M., Burbach, G., Darsow, U., Durham, S., Fokkens, W., Gjomarkaj, M., & Haahtela, T. (2013). The skin prick test—European standards. Clinical and Translational Allergy, 3, Article 3.
Publisher | Google Scholor - Hudzicki, J. (2009). Kirby–Bauer disk diffusion susceptibility test protocol.
Publisher | Google Scholor - Jorgensen, J. H. (1993). Selection criteria for an antimicrobial susceptibility testing system. Journal of Clinical Microbiology, 31(11):2841–2844.
Publisher | Google Scholor - Kapoor, V. (2005). Herbal cosmetics for skin and hair care.
Publisher | Google Scholor - Langmuir, D. (1971). Eh–pH determination. In Procedures in sedimentary petrology (597–635).
Publisher | Google Scholor - Molyneux, P. (2004). The use of the stable free radical diphenylpicrylhydrazyl (DPPH) for estimating antioxidant activity. Songklanakarin Journal of Science and Technology, 26(2):211–219.
Publisher | Google Scholor - Müller, R. H., Mäder, K., & Gohla, S. (2000). Solid lipid nanoparticles (SLN) for controlled drug delivery: A review of the state of the art. European Journal of Pharmaceutics and Biopharmaceutics, 50(1):161–177.
Publisher | Google Scholor - Peters, G. A., & Silverman, J. J. (1946). Role of histamine and acetylcholine in the mechanism of heat allergy: Report of studies on a soldier. Archives of Internal Medicine, 77(4):526–543.
Publisher | Google Scholor - Reller, L. B., Weinstein, M., Jorgensen, J. H., & Ferraro, M. J. (2009). Antimicrobial susceptibility testing: A review of general principles and contemporary practices. Clinical Infectious Diseases, 49(11):1749–1755.
Publisher | Google Scholor - Rivers, J. (2008). The role of cosmeceuticals in antiaging therapy. Skin Therapy Letter, 13(8):5–9.
Publisher | Google Scholor - Sharma, O. P., & Bhat, T. K. (2009). DPPH antioxidant assay revisited. Food Chemistry, 113(4):1202–1205.
Publisher | Google Scholor - Shu, Y.-Z. (1998). Recent natural products-based drug development: A pharmaceutical industry perspective. Journal of Natural Products, 61(8):1053–1071.
Publisher | Google Scholor - Skoner, D. P. (2001). Allergic rhinitis: Definition, epidemiology, pathophysiology, detection, and diagnosis. Journal of Allergy and Clinical Immunology, 108(1):S2–S8.
Publisher | Google Scholor - Verma, S., & Singh, S. (2008). Current and future status of herbal medicines. Veterinary World, 1(11):347–350.
Publisher | Google Scholor